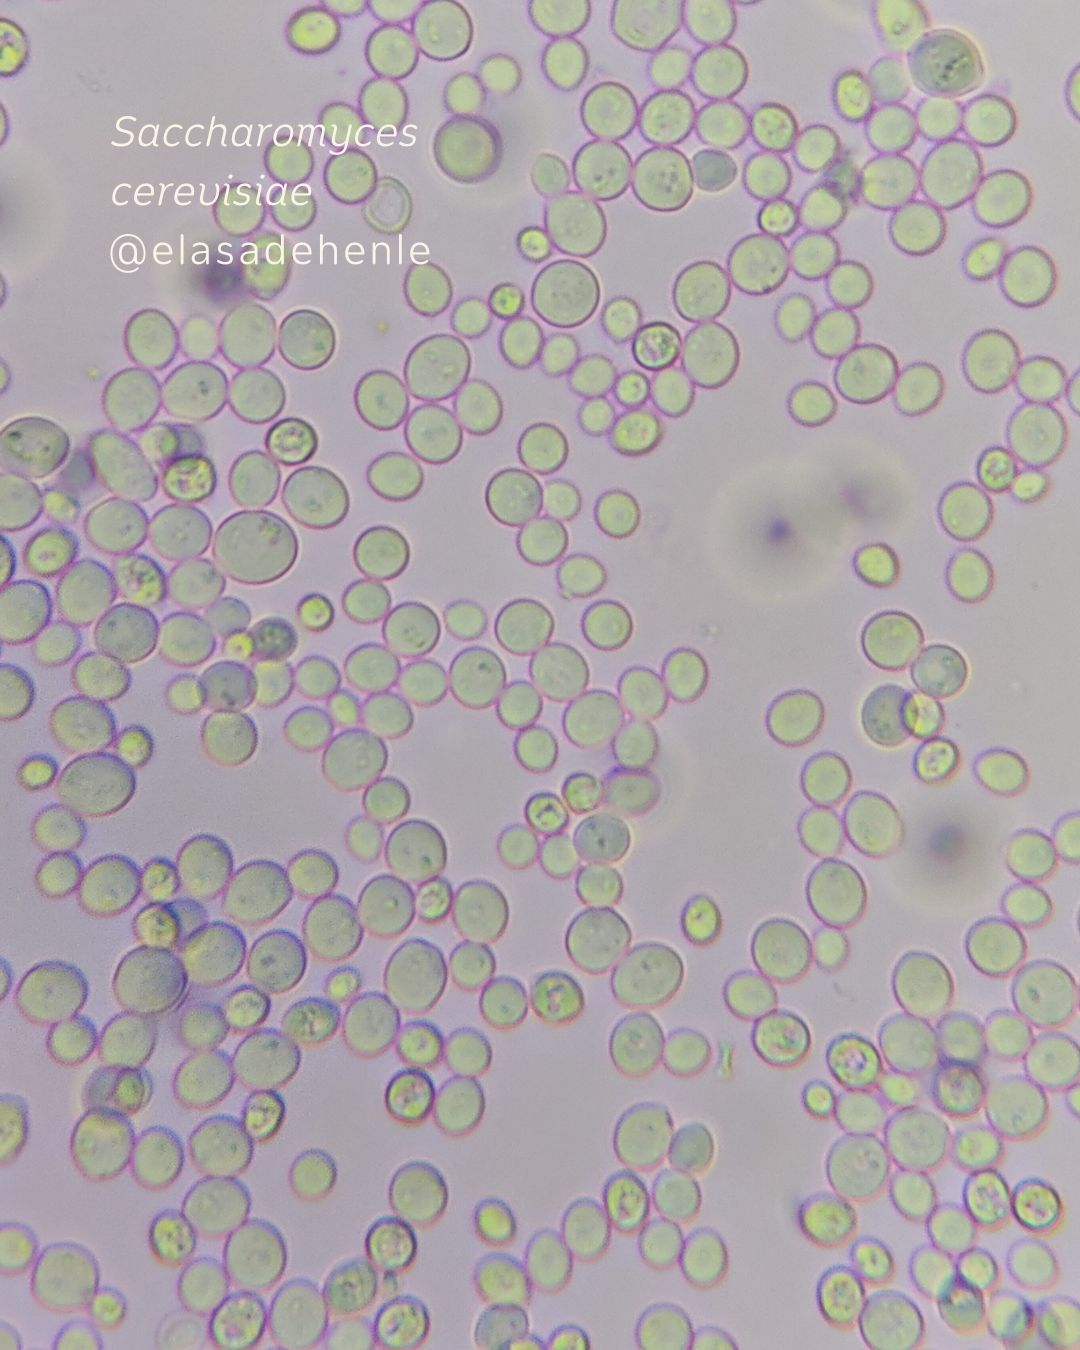

Formaciones teórico – prácticas dirigidas a docentes de educación media y profesionales de áreas afines. A través del aprender haciendo buscamos potenciar el aula con prácticas vinculadas a la histología y microscopía.
Son para vos sí
- Querés aprender a elaborar preparados histológicos transitorios, fijos y semipermanentes de calidad e identificar las estructuras presentes en los mismos.
- Querés familiarizarte con técnicas histológicas con una sólida base teórico – práctica que te permitirá obtener preparados de excelente calidad y ajustar procedimientos para obtener resultados óptimos
Instituciones & Departamentos en los que hemos desarrollado actividades



PROPUESTAS
01. Histología preparados definitivos & semipermanentes / 02. Histología Kits innovadores (preparados transitorios & semipermanentes).
Técnicas: Hematoxilina y eosina, safranina.



03. Demostración histológica de lípidos
Técnica: Sudán III



04. Técnicas para observar cromosomas mitóticos vegetales
Técnica: Hematoxilina y/o orceína.



05. Técnica de Gram aplicada al yogur
Técnica: Gram



05. FIJI para profesores: Estrategias didácticas para analizar microfotografías

06. Histología: preparados frescos
Un taller virtual y asincrónico donde abordamos técnicas sencillas para elaborar preparados transitorios poco convencionales. Módulos: Bacterias, Esclereidas, Almidón, Lípidos, Levaduras